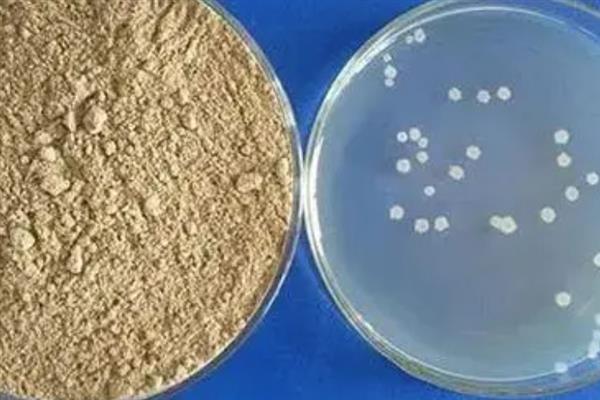

枯草芽孢杆菌对农作物有什么作用,有抗拮、杀菌溶菌的作用
抗拮作用:增强作物的抗重茬能力,抑制某些病原菌的生长和繁殖。
杀菌溶菌:枯草芽孢杆菌会与病原菌的菌丝同时生长,导致病原菌被消耗、分解、菌丝断裂,对于小麦白粉病、水稻稻瘟病等病害具有防效。
调节生长:枯草芽孢杆菌繁殖时,所产生的类似植物生长激素等物质能加快植物的生长速度,增强对病原菌的抵抗能力。

一、枯草芽孢杆菌对农作物有什么作用
1、抗拮作用
(1)使用枯草芽孢杆菌可高抗重茬,它在生长期间可以分泌细菌素(多粘菌素、制霉菌素、枯草菌素)、有机酸类物质、脂肽类化合物,这些物质可以抑制病原菌的生长,或将其溶解。
(2)枯草芽孢杆菌分泌出来的“几丁质酶抗菌蛋白”可抑制多种植物病原菌。
(3)枯草芽孢杆菌可通过争夺空间、养分等方法达到对致病菌的竞争性抑制。

2、杀菌溶菌
(1)枯草芽孢杆菌可伴随病原菌的菌丝一起生长,从而消耗、分解病原菌,导致其菌丝发生断裂,防止病菌进一步危害作物。
(2)枯草芽孢杆菌可以防治病害,比如小麦白粉病,水稻稻瘟病、赤霉病、纹枯病、炭疽病,黄瓜霜霉病,番茄青枯病、灰霉病等。
3、调节生长
枯草芽孢杆菌在繁殖过程中,可产生类似植物生长激素、细胞分裂素的物质,比如增加赤霉素、吲哚乙酸等内源激素的含量,降低脱落酸的含量,这对植物的生长具有促进作用,还有利于植物抵抗病原菌的侵染。

二、枯草芽孢杆菌使用方式
1、拌种
种植西瓜、黄瓜、西红柿、茄子等蔬菜,时可在播种前用枯草芽孢杆菌悬浮种衣剂(300亿芽孢/毫升)和种子按照1:50(或1:100)的比例做拌种处理,拌种后可在种子外部形成保护层,从而达到抑制枯萎病、根腐病等土传病菌侵染种子的效果。

2、喷雾
防治稻瘟病、黑胫病、赤星病、黄萎病、枯萎病等病害,可在发病初期亩用7.5-10枯草芽孢杆菌可湿性粉剂(2000亿CFU/克)兑水30公斤进行喷雾,每隔7天喷1次,连喷2-3次即可。

3、灌根
西红柿、黄瓜、茄子、西瓜等枯萎病发生前或发生初期,亩用200-250克枯草芽孢杆菌可湿性粉剂(100亿/克)兑适量清水做灌根处理即可。

三、枯草芽孢杆菌防治对象
1、枯草芽孢杆菌防治对象:青枯病、溃疡病、性软腐、性穿孔等性病害。

2、枯草芽孢杆菌广泛适用于果树、蔬菜、园林花卉、中药材及大田作物。尤其适合无公害、绿色产品的生产。







